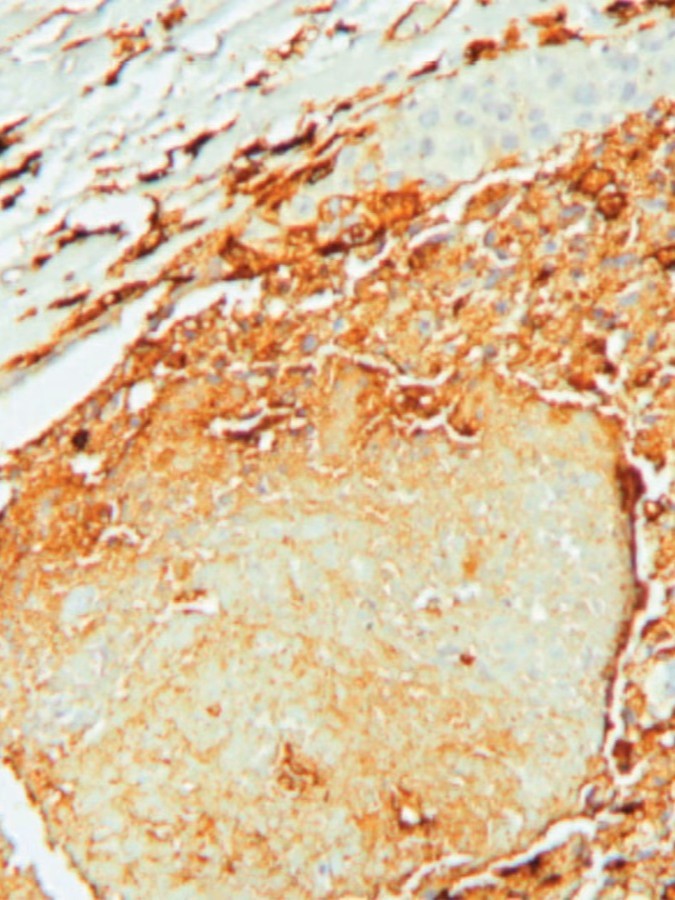
السرطان يربك الساعة البيولوجية للدماغ ويضعف استجابة الجسم

قالت السلطات المغربية إن "تدفقات فيضانية استثنائية" ناجمة عن أمطار غزيرة أودت بحياة 21 شخصاً على الأقل، الأحد، في إقليم آسفي الساحلي المطل على المحيط الأطلسي، والواقع على بعد 330 كيلومتراً جنوبي الرباط، وذلك بعد 7 سنوات من جفاف شهده المغرب.
وأضافت السلطات المحلية بإقليم آسفي، في بيان، "تم تسجيل إسعاف 32 شخصاً مصاباً، غادر غالبيتهم المستشفى بعد تلقي الإسعافات والعلاجات اللازمة، فيما لا تزال الحالات المتبقية تحت المراقبة الطبية".
وأوضحت أن الأمطار الغزيرة التي استمرت ساعة واحدة أدت إلى غمر نحو 70 منزلاً ومتجراً بالمياه، وجرف 10 سيارات، وقطع الكثير من الطرق في مدينة آسفي وضواحيها، في حين تتواصل جهود الإنقاذ.
ويشهد المغرب هطول أمطار غزيرة وتساقطاً للثلوج على جبال الأطلس، وذلك بعد 7 سنوات من الجفاف الذي تسبب في إفراغ بعض سدوده.....
لقراءة المقال بالكامل، يرجى الضغط على زر "إقرأ على الموقع الرسمي" أدناه
هذا المحتوى مقدم من الشرق للأخبار